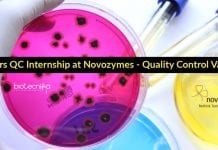
Freshers QC Internship at Novozymes – Quality Control Vacancy Freshers QC Internship

Do Gut bacteria Play Any Role In COVID-19?
Relationship between Gut bacteria and COVID-19
Researchers have implicated that gut bacteria in a number of diseases. There are many studies focused on the relationships...
Kids More Resilient Against Coronavirus: Study Reveals
Children more resilient against coronavirus
New research shows that most children with COVID-19 are resilient against coronavirus, children in 26 nations prospered clinically contrasted to...
Scientists Identify Novel ‘Glial Bar Code’ To Study Brain Cells
Molecular Markers for Glial Cells Identified
One of the major challenges in promoting and restoring the normal function of the nervous system following injuries, diseases,...
Scientists Call For Retraction Of COVID-19 Study In A Major Journal
Retraction Of COVID-19 Study In A Major Journal
A team of leading scientists is calling on a journal to withdraw a paper on the efficiency...
The Impact Of Next Generation Sequencing On Human Health And Agriculture
Next-Generation Sequencing (NGS) denotes high-throughput sequencing in a massively parallel fashion that brought a huge impact at far lower cost using a variety of...
Gujarat Forensic Science University Online Applications Invited For JRF Post
GFSU JRF Post - Online Applications Invited
GFSU JRF Post - Online Applications Invited. Gujarat Forensic Science University Junior Research Fellow Jobs. JRF Vacancy at...
RCB – Regional Centre for Biotechnology SRF Post For Life Sciences
RCB SRF Vacancy Latest - Biotech & Life Sciences Apply Online
RCB SRF Vacancy Latest - Biotech & Life Sciences Apply Online. RCB is hiring...
Government DRDO-DRL Biotech / Food Tech & Microbiology Research Associate
Government DRDO-DRL Biotech / Food Tech & Microbiology Research Associate
Government DRDO-DRL Biotech / Food Tech & Microbiology Research Associate. DRDO-DRL requires Food Technology /...
Govt JRF Job at Silk Board – Non-NET MSc Biotech & Mol Biology Eligible
Govt JRF Job at Silk Board - For Non-NET MSc Biotech & Mol Biology
Govt JRF Job at Silk Board - For Non-NET MSc Biotech...
Freshers QC Internship at Novozymes – Quality Control Vacancy
Freshers QC Internship at Novozymes - Quality Control Vacancy
Freshers QC Internship at Novozymes - Quality Control Vacancy. Candidates with an msc microbiology can apply....
TMC-ACTREC Scientific Officer Recruitment – MSc Genetics / Biotech Apply
ACTREC Scientific Officer Recruitment - Non-NET MSc Candidates Eligible
ACTREC Scientific Officer Recruitment - Non-NET MSc Candidates Eligible. ACTREC hiring for Scientific Officer vacancy. ACTREC...
Biotecnika Times – Newsletter 29.06.2020 – DRDO-DRDE Hiring Msc, Freshers Govt Silk Board Job
Biotecnika Times - DRDO-DRDE Hiring Msc, Freshers Govt Silk Board Job
Govt DRDO-DRDE Research Fellowships 2020 – Life Sciences & Biotech Apply
Govt DRDO-DRDE Research Fellowships...
Fat Binding Protein – ApoE4 Rises the Risk of Alzheimer’s Disease
Why ApoE4 Rises the Threat of Alzheimer's Disease?
The proteins that transport lipids by binding to them are called Apolipoproteins (Apos). Additionally, they can serve...
Scientists Provide New Insights Into DNA Replication Dynamics In Cells
DNA Replication Dynamics in Cells Characterized at Nano Scale
DNA replication is a process that must be coordinated very precisely to ensure that the genome...
MIT Researchers Design Peptides To Target And Degrade Coronavirus
Researchers at the MIT Media Lab and Center for Bits and Atoms, using computational models of protein interactions, designed peptides that can target coronavirus...